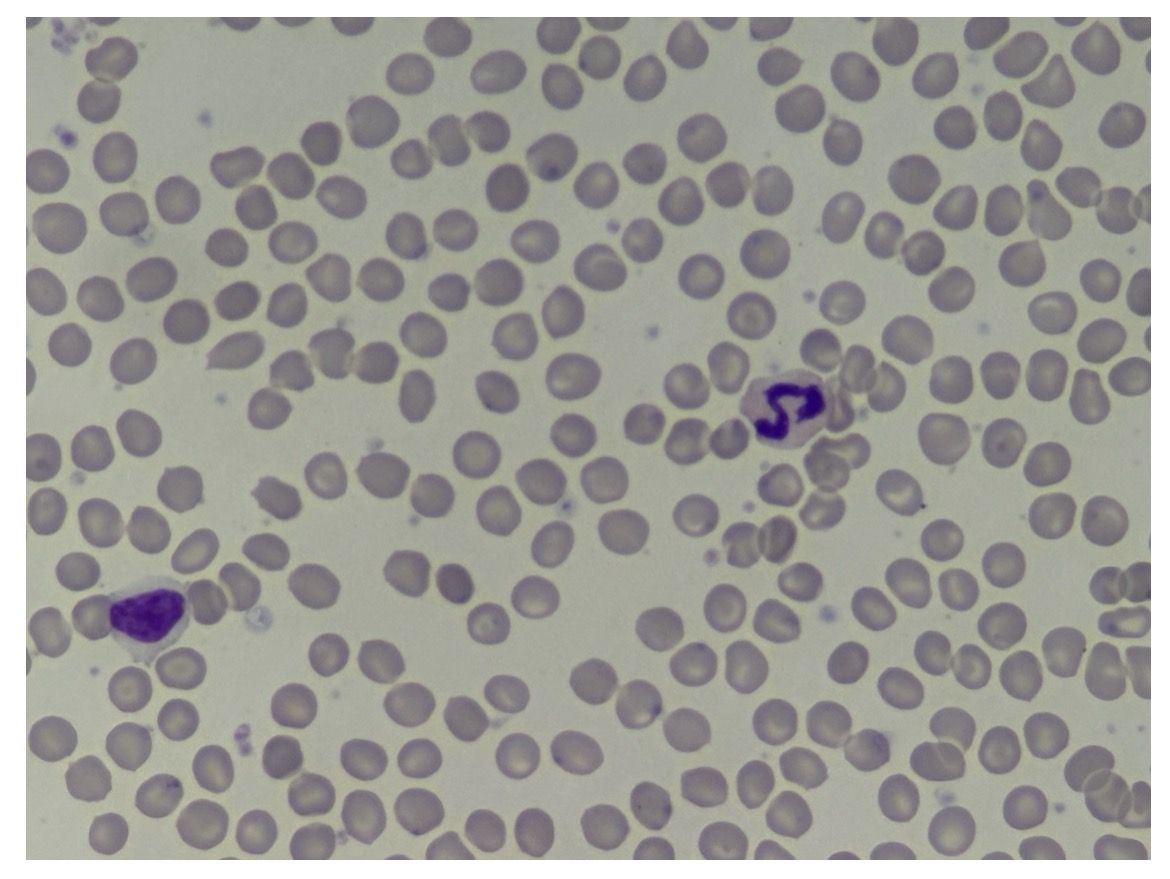
Foto2

Ehrung der Teilnehmerinnen und Teilnehmer
In diesem Jahr haben Kim Lanser, Dinah Weber, Leander Dani und Tim Valentin an der Internationalen BiologieOlympiade teilgenommen.

(Foto: Michael Sexauer)
Die Internationale BiologieOlympiade ist ein jährlich stattfindender, globaler Wettbewerb, in dem sich Schülerinnen und Schüler leistungsorientiert mit Aufgaben und Lernangeboten aus der Biologie auseinandersetzen. Der Wettbewerb erstreckt sich über vier Runden, die jeweils in unterschiedlichen Formaten gestaltet sind.
In der ersten Runde bearbeiten die Schülerinnen und Schüler die gestellten Aufgaben selbständig in der Form einer Hausarbeit. In diesem Jahr bezogen sich die Aufgaben auf die Themen Honigbiene, Organspende, Backhefe und Schlaf. Die 400 besten Teilnehmerinnen und Teilnehmer aus Deutschland, zu denen auch unsere vier Schülerinnen und Schüler zählten, haben in der zweiten Runde eine zweistündige multiple-choice-Klausur absolviert, die weit über den Unterrichststoff der Oberstufe hinausging. Wegen ihres guten Abschneidens in der zweiten Runde wurden Leander Dani und Tim Valentin zu einem dreitägigen Praktikum an die Universität Kaiserslautern eingeladen. Sie berichteten Folgendes:
Vom 05.02.2026 bis zum 06.02.2026 fand im Fachbereich Biologie der RPTU Kaiserslautern ein Praktikum für die 15 besten rheinland-pfälzischen Teilnehmerinnen und Teilnehmer der zweiten Runde der Internationalen Biologie-Olympiade 2026 statt. In diesem Jahr hatten wir die Möglichkeit, daran teilzunehmen und spannende Einblicke in die Bereiche Humanbiologie, Cytologie, computergestützte Systembiologie sowie Mikrobiologie und Genetik zu gewinnen. Besonders bereichernd war, dass wir unter Anleitung von Dozenten und Assistenten eigenständig Experimente in den jeweiligen Laboren durchführen konnten. Zudem wurde uns das Biologiestudium immer wieder nähergebracht. Nach unserer Ankunft am ersten Tag beschäftigten wir uns zunächst mit der Alzheimer-Demenz und mikroskopierten anschließend sowohl Schweinegehirn als auch Alzheimer-betroffenes Mausgehirn. Dabei konnten wir charakteristische Merkmale von Alzheimer-Gehirnen erkennen, wobei die genauen Entstehungsmechanismen dieser Veränderungen nach wie vor nicht vollständig geklärt sind.
Im weiteren Verlauf entnahmen wir uns selbst Blutproben und machten durch verschiedene Färbemethoden einzelne Bestandteile sichtbar.
Untergebracht waren wir im Internat des Heinrich-Heine-Gymnasiums, wo wir den Abend – nach einem etwas gewöhnungsbedürftigen Abendessen – gemeinsam mit den anderen Teilnehmenden ausklingen lassen konnten.
Der zweite Tag begann nicht im Labor, sondern im Computerraum. Dort trainierten wir mithilfe von Mikroskopbildern unsere eigene künstliche Intelligenz, um verschieden markierte Zellen voneinander zu unterscheiden.
Das Highlight der beiden Tage war für uns der abschließende Programmpunkt mit PD Dr. Michelle Gehringer, die uns besonders für ihren Fachbereich Mikrobiologie begeistern konnte. Im Großraumlabor führten wir zahlreiche Versuche durch, darunter das Fluoreszieren von Cyanobakterien sowie Experimente zur Wirkung von Antibiotika auf das Wachstum von Bakterien.

Wir bedanken sehr für die Möglichkeit, an diesen zwei äußerst interessanten und lehrreichen Tagen teilnehmen zu dürfen!
(Fotos und Text: Leander Dani und Tim Valentin)
Schulleiter Michael Sexauer gratulierte Ende Februar den diesjährigen Teilnehmerinnen und Teilnehmern zu ihren Erfolgen und überreichte ihnen ihre Urkunden. Betreut wurden die Schülerinnen und Schüler von ihren Biologie-Lehrerinnen Steffi Schäfer und Beate Gottwald.
(Beate Gottwald)